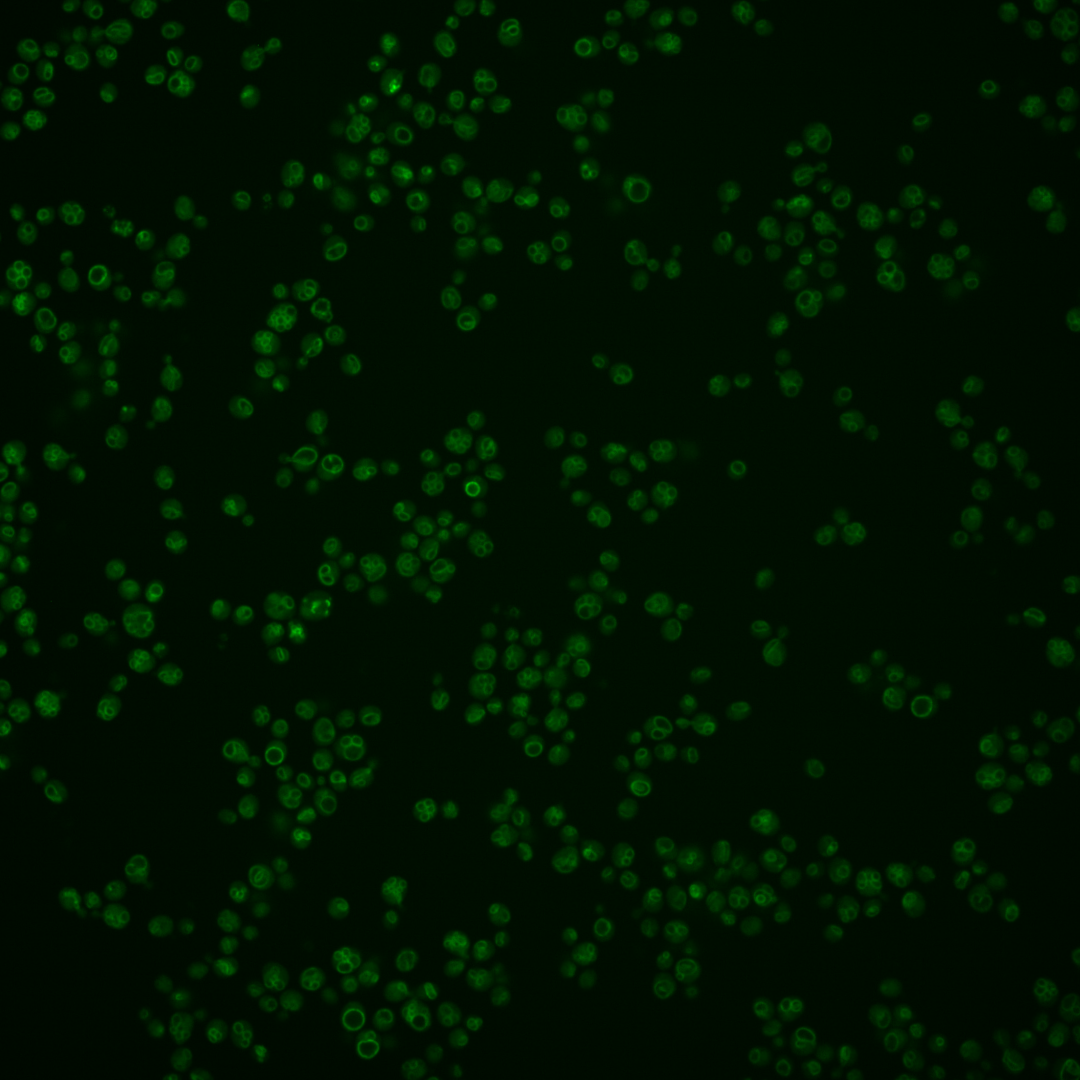
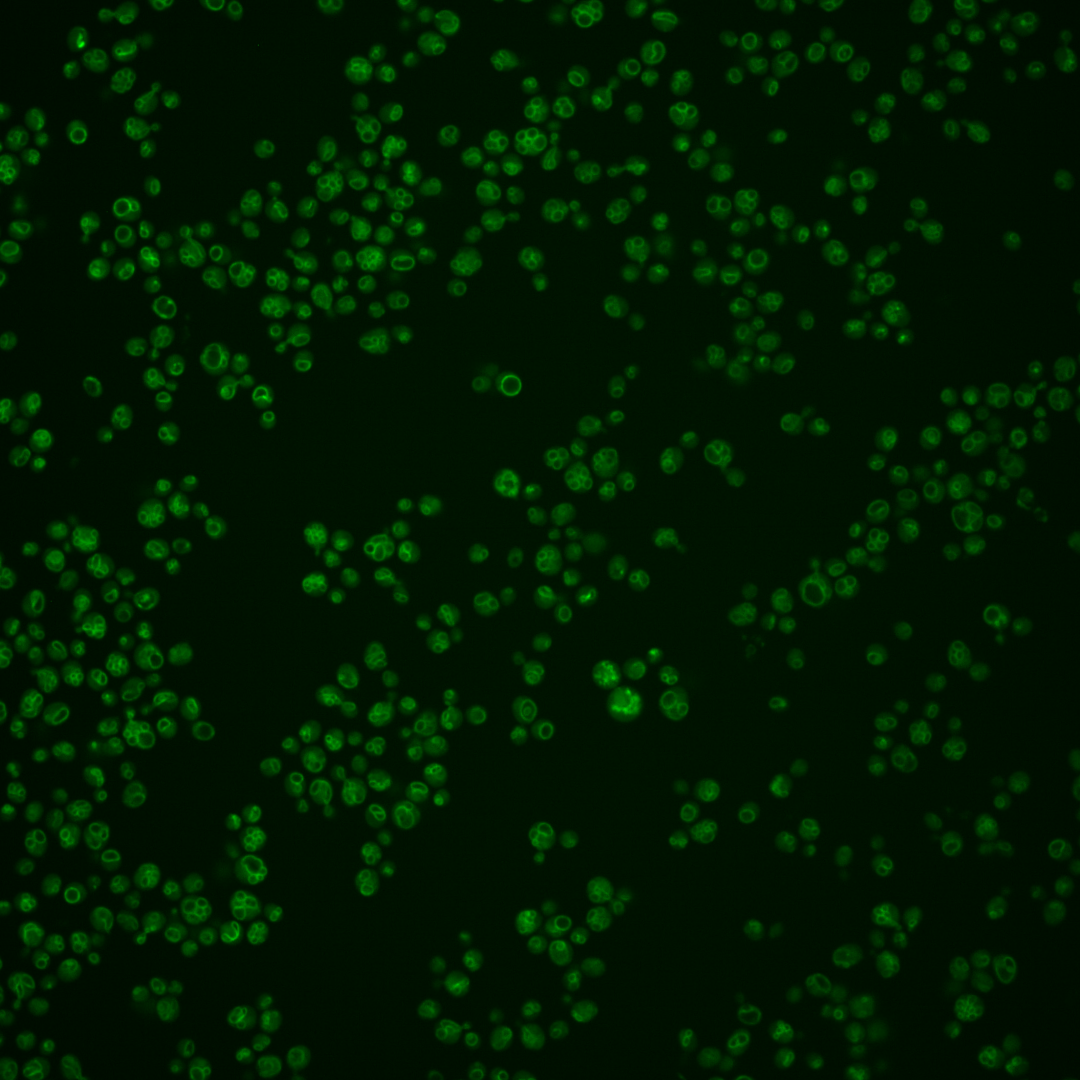
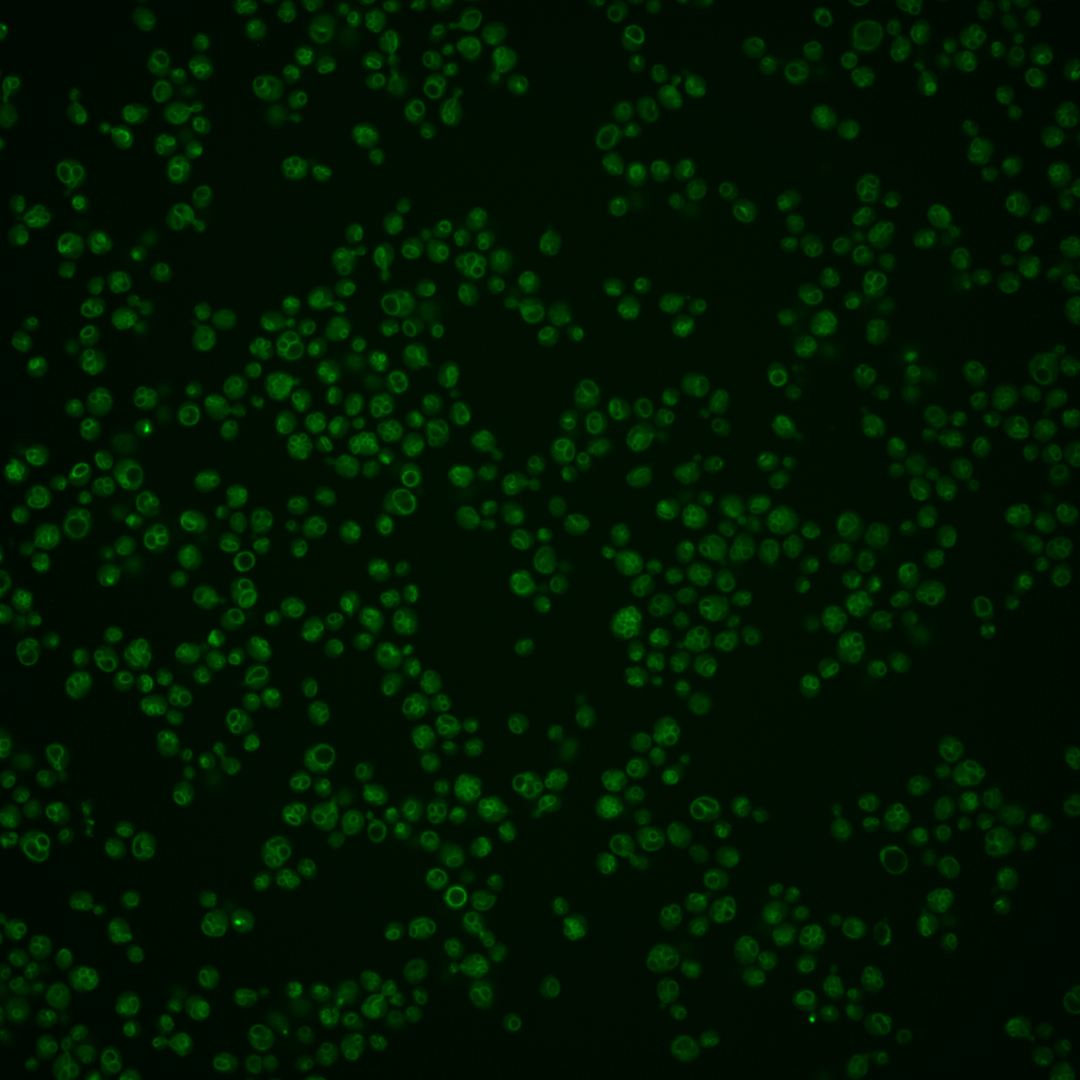
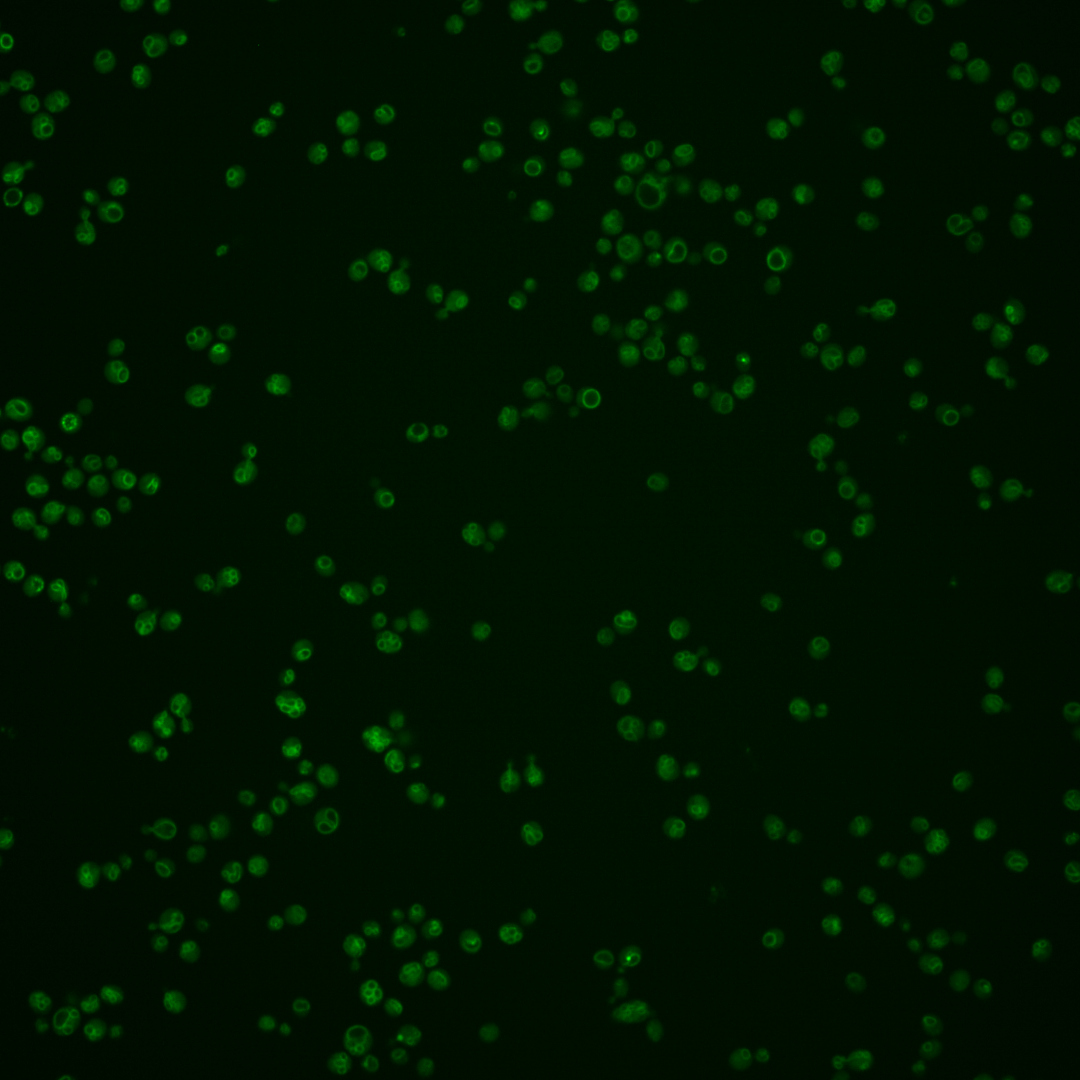

| Standard name | |
|---|---|
| Human Ortholog | |
| Description | Ribosomal 60S subunit protein L27A; homologous to mammalian ribosomal protein L27, no bacterial homolog; RPL27A has a paralog, RPL27B, that arose from the whole genome duplication |
Micrographs




















































































Sub-cellular Localization
Yeast GFP Assignment
Protein Abundance
Localization Change
External localization resources
| ensLOC | DeepLoc | |||||||||||||||||||||||
|---|---|---|---|---|---|---|---|---|---|---|---|---|---|---|---|---|---|---|---|---|---|---|---|---|
| Localization | WT1 | WT2 | WT3 | RAP60 | RAP140 | RAP220 | RAP300 | RAP380 | RAP460 | RAP540 | RAP620 | RAP700 | HU80 | HU120 | HU160 | rpd3Δ_1 | rpd3Δ_2 | rpd3Δ_3 | WT1 | WT2 | WT3 | AF100 | AF140 | AF180 |
| Cortical Patches | 0 | 0 | – | – | 0 | 0 | 0 | 0 | – | 0 | 0 | – | 0 | 0 | 0 | 0 | 0 | – | 0 | 0 | 0 | 0 | 0 | 0 |
| Bud | 1 | 1 | – | – | 0 | 0 | 0 | 3 | – | 3 | 4 | – | 0 | 0 | 0 | 0 | 0 | – | 6 | 0 | 3 | 0 | 0 | 0 |
| Bud Neck | 0 | 0 | – | – | 0 | 0 | 0 | 2 | – | 0 | 0 | – | 0 | 0 | 0 | 0 | 0 | – | 1 | 0 | 0 | 0 | 0 | 0 |
| Bud Site | 0 | 0 | – | – | 0 | 0 | 0 | 1 | – | 0 | 1 | – | 0 | 0 | 0 | 0 | 0 | – | – | – | – | – | – | – |
| Cell Periphery | 0 | 0 | – | – | 1 | 1 | 1 | 0 | – | 0 | 0 | – | 0 | 6 | 10 | 1 | 0 | – | 0 | 0 | 0 | 0 | 0 | 0 |
| Cytoplasm | 44 | 19 | – | – | 28 | 46 | 35 | 48 | – | 18 | 12 | – | 55 | 122 | 126 | 21 | 16 | – | 60 | 30 | 28 | 58 | 61 | 91 |
| Endoplasmic Reticulum | 0 | 0 | – | – | 0 | 0 | 0 | 1 | – | 1 | 0 | – | 1 | 3 | 0 | 0 | 2 | – | 3 | 0 | 0 | 3 | 1 | 3 |
| Endosome | 11 | 0 | – | – | 0 | 0 | 0 | 3 | – | 0 | 0 | – | 1 | 0 | 0 | 2 | 1 | – | 16 | 2 | 5 | 0 | 0 | 1 |
| Golgi | 0 | 1 | – | – | 0 | 0 | 0 | 0 | – | 0 | 0 | – | 0 | 1 | 0 | 0 | 0 | – | 1 | 1 | 0 | 0 | 1 | 0 |
| Mitochondria | 11 | 0 | – | – | 0 | 25 | 28 | 38 | – | 38 | 36 | – | 0 | 0 | 0 | 0 | 0 | – | 2 | 0 | 1 | 1 | 1 | 2 |
| Nucleus | 5 | 0 | – | – | 0 | 0 | 0 | 3 | – | 2 | 1 | – | 0 | 1 | 0 | 0 | 0 | – | 17 | 7 | 0 | 0 | 0 | 0 |
| Nuclear Periphery | 1 | 0 | – | – | 0 | 0 | 0 | 0 | – | 0 | 0 | – | 0 | 0 | 0 | 0 | 0 | – | 3 | 0 | 1 | 0 | 0 | 0 |
| Nucleolus | 21 | 2 | – | – | 0 | 1 | 2 | 2 | – | 4 | 4 | – | 0 | 0 | 1 | 0 | 0 | – | 10 | 1 | 3 | 0 | 0 | 0 |
| Peroxisomes | 0 | 0 | – | – | 0 | 0 | 0 | 0 | – | 0 | 0 | – | 0 | 0 | 0 | 0 | 0 | – | 0 | 0 | 0 | 0 | 0 | 0 |
| SpindlePole | 0 | 0 | – | – | 0 | 0 | 1 | 2 | – | 1 | 1 | – | 0 | 0 | 0 | 0 | 0 | – | 12 | 1 | 6 | 1 | 0 | 0 |
| Vac/Vac Membrane | 36 | 6 | – | – | 0 | 4 | 0 | 6 | – | 8 | 5 | – | 1 | 2 | 0 | 4 | 2 | – | 16 | 13 | 2 | 1 | 1 | 2 |
| Unique Cell Count | 105 | 27 | 29 | 62 | 51 | 88 | 56 | 49 | 57 | 126 | 127 | 25 | 18 | 157 | 61 | 61 | 69 | 71 | 106 | |||||
| Labelled Cell Count | 130 | 29 | 29 | 77 | 67 | 109 | 75 | 64 | 58 | 135 | 137 | 28 | 21 | 157 | 61 | 61 | 69 | 71 | 106 | |||||
Yeast GFP Assignment
Protein Abundance
| Screen | WT1 | WT2 | WT3 | RAP60 | RAP140 | RAP220 | RAP300 | RAP380 | RAP460 | RAP540 | RAP620 | RAP700 | HU80 | HU120 | HU160 | rpd3Δ_1 | rpd3Δ_2 | rpd3Δ_3 | AF100 | AF140 | AF180 |
|---|---|---|---|---|---|---|---|---|---|---|---|---|---|---|---|---|---|---|---|---|---|
| Mean Cell GFP Intensity (1e-4) | 7.7 | 14.8 | – | – | 9.1 | 5.8 | 5.4 | 5.9 | – | 5.2 | 5.7 | – | 8.8 | 9.5 | 9.4 | 22.3 | 9.8 | – | 9.3 | 9.2 | 10.0 |
| Std Deviation (1e-4) | 1.7 | 5.3 | – | – | 2.0 | 1.2 | 1.1 | 1.6 | – | 1.4 | 1.5 | – | 1.7 | 1.6 | 1.9 | 35.9 | 1.7 | – | 2.1 | 1.9 | 2.2 |
| Intensity Change (Log2) | – | – | – | – | – | – | – | – | – | – | – | – | – | – | – | – | – | – | – | – | – |
Localization Change
| Localization | RAP60 | RAP140 | RAP220 | RAP300 | RAP380 | RAP460 | RAP540 | RAP620 | RAP700 | HU80 | HU120 | HU160 | rpd3Δ_1 | rpd3Δ_2 | rpd3Δ_3 |
|---|---|---|---|---|---|---|---|---|---|---|---|---|---|---|---|
| Actin | – | – | – | – | – | – | – | – | – | – | – | – | – | – | – |
| Bud | – | – | – | – | – | – | – | – | – | – | – | – | – | – | – |
| Bud Neck | – | – | – | – | – | – | – | – | – | – | – | – | – | – | – |
| Bud Site | – | – | – | – | – | – | – | – | – | – | – | – | – | – | – |
| Cell Periphery | – | – | – | – | – | – | – | – | – | – | – | – | – | – | – |
| Cyto | – | – | – | – | – | – | – | – | – | – | – | – | – | – | – |
| Endoplasmic Reticulum | – | – | – | – | – | – | – | – | – | – | – | – | – | – | – |
| Endosome | – | – | – | – | – | – | – | – | – | – | – | – | – | – | – |
| Golgi | – | – | – | – | – | – | – | – | – | – | – | – | – | – | – |
| Mitochondria | – | – | – | – | – | – | – | – | – | – | – | – | – | – | – |
| Nuclear Periphery | – | – | – | – | – | – | – | – | – | – | – | – | – | – | – |
| Nuc | – | – | – | – | – | – | – | – | – | – | – | – | – | – | – |
| Nucleolus | – | – | – | – | – | – | – | – | – | – | – | – | – | – | – |
| Peroxisomes | – | – | – | – | – | – | – | – | – | – | – | – | – | – | – |
| SpindlePole | – | – | – | – | – | – | – | – | – | – | – | – | – | – | – |
| Vac | – | – | – | – | – | – | – | – | – | – | – | – | – | – | – |
| Cortical Patches | – | – | – | – | – | – | – | – | – | – | – | – | – | – | – |
| Cytoplasm | – | – | – | – | – | – | – | – | – | – | – | – | – | – | – |
| Nucleus | – | – | – | – | – | – | – | – | – | – | – | – | – | – | – |
| Vacuole | – | – | – | – | – | – | – | – | – | – | – | – | – | – | – |
External localization resources
Images






























Protein Concentration and Protein Localization Data
| R1 | R2 | R3 | ||||||||||||||||
|---|---|---|---|---|---|---|---|---|---|---|---|---|---|---|---|---|---|---|
| G1 Pre-START | G1 Post-START | S/G2 | Metaphase | Anaphase | Telophase | G1 Pre-START | G1 Post-START | S/G2 | Metaphase | Anaphase | Telophase | G1 Pre-START | G1 Post-START | S/G2 | Metaphase | Anaphase | Telophase | |
| Concentration | – | – | – | – | – | – | – | – | – | – | – | – | – | – | – | – | – | – |
| Actin | – | – | – | – | – | – | – | – | – | – | – | – | – | – | – | – | – | – |
| Bud | – | – | – | – | – | – | – | – | – | – | – | – | – | – | – | – | – | – |
| Bud Neck | – | – | – | – | – | – | – | – | – | – | – | – | – | – | – | – | – | – |
| Bud Periphery | – | – | – | – | – | – | – | – | – | – | – | – | – | – | – | – | – | – |
| Bud Site | – | – | – | – | – | – | – | – | – | – | – | – | – | – | – | – | – | – |
| Cell Periphery | – | – | – | – | – | – | – | – | – | – | – | – | – | – | – | – | – | – |
| Cytoplasm | – | – | – | – | – | – | – | – | – | – | – | – | – | – | – | – | – | – |
| Cytoplasmic Foci | – | – | – | – | – | – | – | – | – | – | – | – | – | – | – | – | – | – |
| Eisosomes | – | – | – | – | – | – | – | – | – | – | – | – | – | – | – | – | – | – |
| Endoplasmic Reticulum | – | – | – | – | – | – | – | – | – | – | – | – | – | – | – | – | – | – |
| Endosome | – | – | – | – | – | – | – | – | – | – | – | – | – | – | – | – | – | – |
| Golgi | – | – | – | – | – | – | – | – | – | – | – | – | – | – | – | – | – | – |
| Lipid Particles | – | – | – | – | – | – | – | – | – | – | – | – | – | – | – | – | – | – |
| Mitochondria | – | – | – | – | – | – | – | – | – | – | – | – | – | – | – | – | – | – |
| None | – | – | – | – | – | – | – | – | – | – | – | – | – | – | – | – | – | – |
| Nuclear Periphery | – | – | – | – | – | – | – | – | – | – | – | – | – | – | – | – | – | – |
| Nucleolus | – | – | – | – | – | – | – | – | – | – | – | – | – | – | – | – | – | – |
| Nucleus | – | – | – | – | – | – | – | – | – | – | – | – | – | – | – | – | – | – |
| Peroxisomes | – | – | – | – | – | – | – | – | – | – | – | – | – | – | – | – | – | – |
| Punctate Nuclear | – | – | – | – | – | – | – | – | – | – | – | – | – | – | – | – | – | – |
| Vacuole | – | – | – | – | – | – | – | – | – | – | – | – | – | – | – | – | – | – |
| Vacuole Periphery | – | – | – | – | – | – | – | – | – | – | – | – | – | – | – | – | – | – |
Sequencing Data
| R1 | R2 | |||||||||
|---|---|---|---|---|---|---|---|---|---|---|
| G1 Post-START | S/G2 | Metaphase | Anaphase | Telophase | G1 Post-START | S/G2 | Metaphase | Anaphase | Telophase | |
| Gene Expression | 2504.8086 | 2426.3414 | 2747.8678 | 2364.5553 | 2718.5111 | 2232.4192 | 2126.8964 | 1958.7816 | 2178.3014 | 1952.276 |
| Translational Efficiency | 1.6633 | 1.7097 | 1.5986 | 1.4843 | 1.7106 | 1.9808 | 1.7353 | 2.1429 | 1.7211 | 2.1266 |
Hit Data
| Dataset | Hit |
|---|---|
| Protein Concentration | – |
| Protein Localization | – |
| Gene Expression | ✘ |
| Translational Efficiency | ✘ |
Endocytosis
| Temp | Actin Patch (Sac6-tdTomato) | Cortical Patch (Sla1-GFP) | Late Endosome (Snf7-GFP) | Vacuole (Vph1-GFP) |
|---|---|---|---|---|
| 37℃ | ||||
| RT |
Cell Cycle Omics
CYCLoPs (Rpl27a-GFP)
| Gene / Allele | Actin Patch (Sac6-tdTomato) | Cortical Patch (Sla1-GFP) | Late Endosome (Snf7-GFP) | Vacuole (Sac6-tdTomato) |
|---|
| Gene | Images |
|---|
| Gene | Images |
|---|
Images are not yet available
Images are not yet available